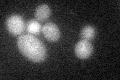
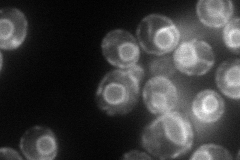
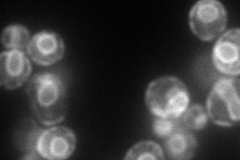
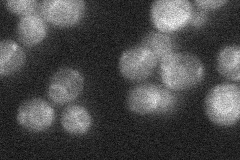

View description
Protein with a role in UDP-galactose transport to the Golgi lumen, has similarity to human UDP-galactose transporter UGTrel1, exhibits a genetic interaction with S. cerevisiae ERO1
Localization:
Intensity:
Fold change:
Significance:
-
C’ GFP library in SD
below threshold17.86 -
N' NOP1pr-GFP in SD
ER100.661 -
N' TEF2pr-mCherry in SD
ER137.832 -
N' NATIVEpr-GFP in SD
ER23.1702 -
N' TEF2pr-VC and Cyto-VN in SD

#N/A0 -
C’ GFP library in SD+DTT

cytosol18.451.03No -
C’ GFP library in SD+H2O2

cytosol17.520.98No -
C’ GFP library in Starvation Media

cytosol17.250.96No -
C’ GFP library on the background of Pup2-DaMP

below threshold -
C’ GFP library on the background of CCT mutant

below threshold16.41620.918536No
